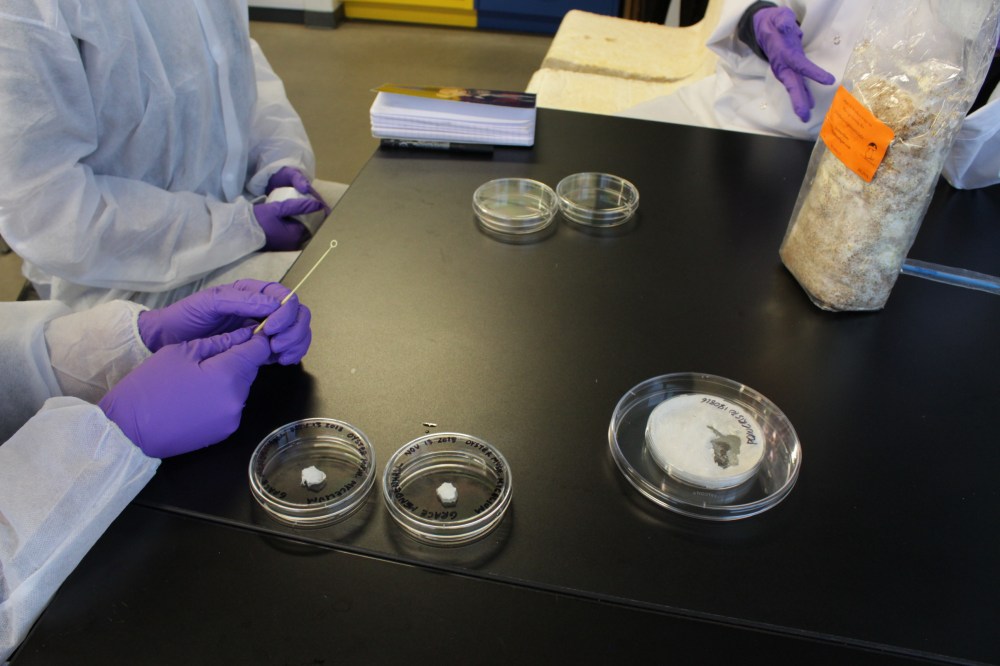

Researcher: Maria Chekahnovich, MFA student, Fibres and Material Practices
Project scope:
“So many objects of our daily lives know but a fleeting presence. What does it mean that much, if notmost, of our ordinary commerce with the world involves destruction?” [1]
Trash/waste/garbage is a uniquely human phenomenon that is harmful and foreign to the natural environment. My research-creation project is dedicated to the understanding of the existence of trash. How does it reflect on the human relationship with the material world, objects that serve us and are then thrown away?
Is the problem of trash caused by a state of disconnection? If so, how can sculpture installations reconstitute a connection between people and trash?

I relate my work to Ecological Art practices, which I perceive to be new forms of Land and Environmental Art; works that are site specific, raise ecological and political issues and reveal the inseparable connection to environment… I use the natural growth process of mushroom roots called mycelium. Why mycelium? In nature, mycelium functions as a decomposer; it adds nutrients to the soil and revives damaged environments. I relate to artists like Aviva Rahmani and Mary Mattingly who practice Aesthetic Activism, which emphasizes the importance of the aesthetic experience as a tool to invoke social, ecological, and political engagement.

Visiting the landfill with an aesthetic eye to social change will result in a new connection towards trash – This experience can offer significant transformation to they way people understand the relationship to the environment through the material world. I believe this can impact consumption habits and the choice of materials we use in daily life.
Cover photo by Miri Chekahnovich
[1] Greg Kennedy. An Ontology of Trash, The disposable and its problematic nature. State University of New York Press, 2007.